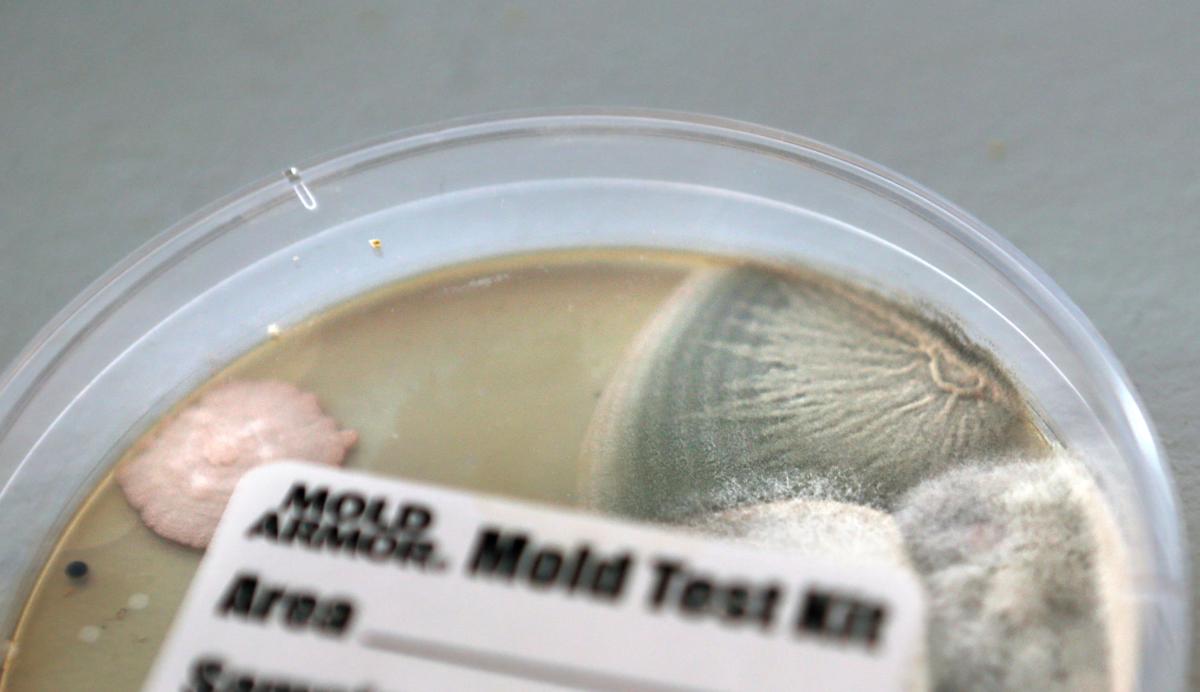
hr dssbuildings 092917 p04

Scattered social services seek one roof instead of three in Franklin County - Roanoke Times


Employees with Franklin County's Department of Social Services, Cannon Morris (left) and Vennaisa Veney, squeeze past each other in a cramped hallway of one of the three buildings in which social service employees work.

Deborah Powell, director of Franklin County's Department of Social Services, speaks in her office.

Franklin County's Department of Social Services wants to get all of its employees under one roof. They hope to relocate to an empty space in the Schewels Franklin Plaza shopping center in Rocky Mount.
Employees of Franklin County's Dept. of Social Services have been feeling sick while in the offices at 5 East Court St.
The Franklin County Department of Social Services will make a plea to county supervisors this month for additional funding needed to bring its 78 employees, currently housed in three different buildings, under one roof.
Though social services employees have been split between multiple buildings for several years, there's a renewed sense of urgency to consolidate after the February sale of one building leased by the department.
When the department's office at 139 E. Court St. was sold, 16 employees moved into the nearby 120 E. Court St. office, a former library. Employees are working in cramped conditions with little room to move about between cubicles and filing cabinets. Director Deborah Powell refers to the bank of cubicles as "the maze."
The sale of the building prompted Powell and three other administrative employees to move into an office at 5 E. Court St. Powell says something in the office is making her and others feel ill, though two tests for mold have come back negative. Often, she said, they can only manage to work in the office for a few hours a day.
Powell believes she and the social services board have identified an alternate location that could solve each problem: Renting a space in Schewels Franklin Plaza, near the county's government center.
The 19,800-square-foot space would require an additional $60,000 a year in local funds. Powell plans to make the official request at the board of supervisors' October meeting.
County Administrator Brent Robertson said a capital improvement work session already planned for the October meeting presents an opportunity for Powell to share the details of the department's plan with the board.
Moving a department is a major undertaking, Robertson said, so the board needs to think in the long term. A new social services building should be able to meet the department's needs for the next 10 to 15 years.
"I understand the need is here, the need is today, they need to do something, but it needs to be done in the context of a complete capital decision," he said.
Robertson said he is obviously concerned about conditions described by Powell, particularly at 5 E. Court St. where employees feel the building is making them sick. He said such conditions are not acceptable, and the county has to mitigate it quickly, perhaps before it can consider the consolidation effort.
"It's kind of hard to debate the need for something to be done," Robertson said, it's just a matter of answering such questions as how, when and how much it will cost.
In making the case for the Schewels space, Powell explained that the cost of the building would also include renovations and that the county could utilize department savings for the project.
The county would pay about $15 per square foot for the Schewels space. Powell said that figure includes the cost of renovations — a new heating and air-conditioning system, flooring, construction of offices and breakrooms, among other things. The space is "pretty much just a shell of a building" currently, Powell said.
Additionally, Powell estimates spending about $100,000 on cubicles and $30,000 for wiring. However, the county would be reimbursed by the state and federal governments for some of those costs.
Powell highlighted savings to offset some of the additional costs. Since 2009, she said, the county has paid over $12,000 for snow removal at its social services properties. The county wouldn't have these fees at the Schewels location. And if the department had only one building, it would eliminate duplicative costs that come with maintaining three.
Powell also noted that the agency typically comes in under budget — roughly $1.5 million over the last five years — largely due to savings from unfilled jobs. She said the county could use some of those savings to cover costs for this fiscal year associated with the move. She said social services likely wouldn't be able to move into the Schewels location until the next fiscal year, which begins in July.
Powell says consolidating social services is better for both employees and clients. There's overlap in social services programs and the department could run more efficiently if all employees worked in the same space. It would also mean clients wouldn't have to visit multiple locations to receive services.
"For a lot of our clients, that's a hardship," Powell said. "They may have limited gas or maybe somebody's giving them a ride and they're thinking they're just going to one place and it's like, 'Oh no now I need to go to another building.' Or they might show up at this building and really need to be down at the other building."
Charles Wagner, vice chairman of the board of supervisors and member of the social services board, said bringing the department together under one roof is the goal, but there are many hoops to jump through before that can be accomplished.
He said it's important for the supervisors to weigh in on the issue, and chart a path forward.
"I think it's a great idea if we can afford it," Wagner said. "At this point, we've just got to look at the cost increase."
Comments
Post a Comment